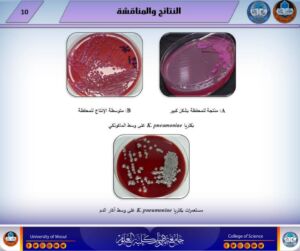
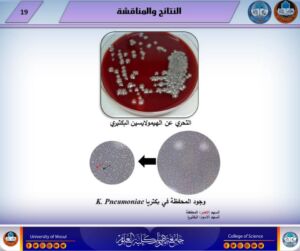

6 ديسمبر، 2024
رسالة ماجستير تناقش التقييم البكتيريولوجي والجزيئي لأنواع بكتريا الكلبسيلا

نوقشت في قسم علوم الحياة بكلية العلوم / جامعة الموصل رسالة الماجستير الموسومة ” التقييم البكتيريولوجي والجزيئي لأنواع بكتريا الكلبسيلا المعزول من مصادر سريرية مختلفة وتثبيط بعض عوامل ضراوتها ” يوم الخميس الموافق 5 كانون الاول 2024، حضر جانبا منها السيد رئيس قسم علوم الحياة المحترم وعدد من تدريسي الكلية المحترمين.
تناولت الرسالة التي تقدمت بها طالبة الماجستير (شيماء تحسين احمد عبد القادر) عزل وتشخيص بكتريا الكلبسيلا الرئوية من مصادر سريرية مختلفة والتحري عن عوامل الضراوة التي تمتلكها مظهريا وجزيئيا والتحري عن مدى مقاومتها تجاه المضادات الحيوية المختلفة ومدى امتلاكها لانزيمات البيتالاكتاميز المختلفة، إضافة إلى محاولة تثبيط بعض عوامل ضراوتها باستخدام مادة N_acetyl l_ cysteine .
بينت الدراسة عزل البكتريا بنسبة ١٢٪ و امتلاكها لأغلب عوامل الضراوة ومقاومتها تجاه مضادات حيوية مختلفة، أظهرت المادة المستخدمة قدرة تثبيطية تجاه اغلب السلالات وقدرة مثبطة لتكوين وإزالة الغشاء الحيوي المتكون وبتراكيز مختلفة.
تراس لجنة المناقشة الاستاذ الدكتور محسن أيوب عيسى العكيدي وعضوية كل من المدرس الدكتورة إيناس عبد المنعم الليلة والأستاذ المساعد نجلاء عبد الله فتحي وبأشراف وعضوية الاستاذ المساعد الدكتور شاكر غازي جرجيس حسين.
تمنياتنا لجميع أساتذتنا وطلبتنا الأعزاء دوام الموفقية والنجاح والتألق العلمي.
شعبة الاعلام والاتصال الحكومي
الجمعة 6 كانون الأول 2024